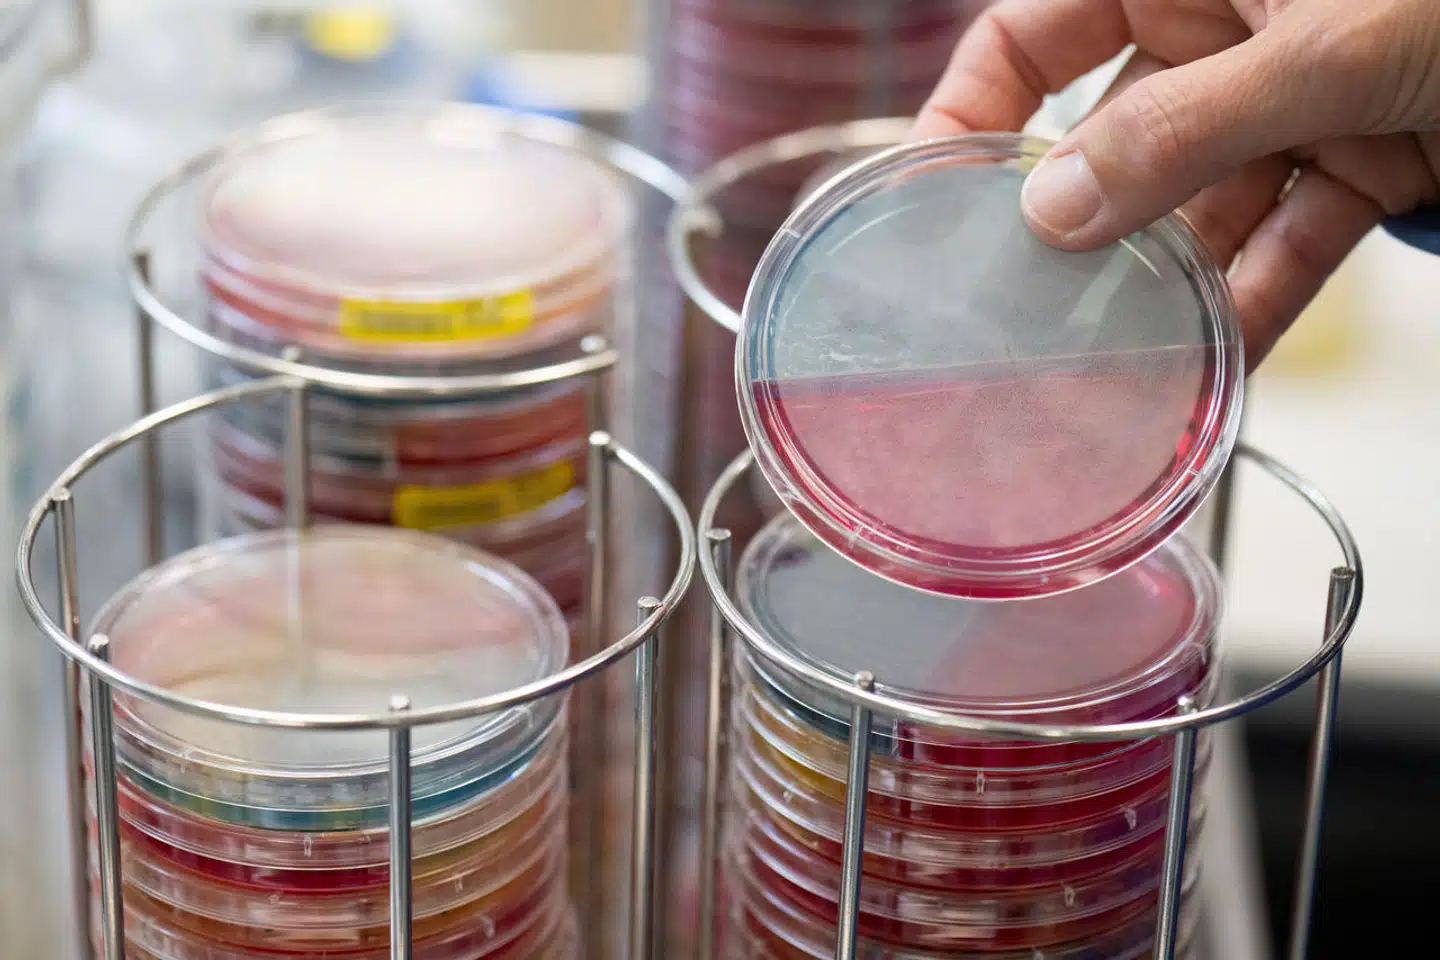
Det sjældne fænomen skyldtes en ubalance i kvindens mikrobiom. Arkivfoto: Boris Roessler, Scanpix
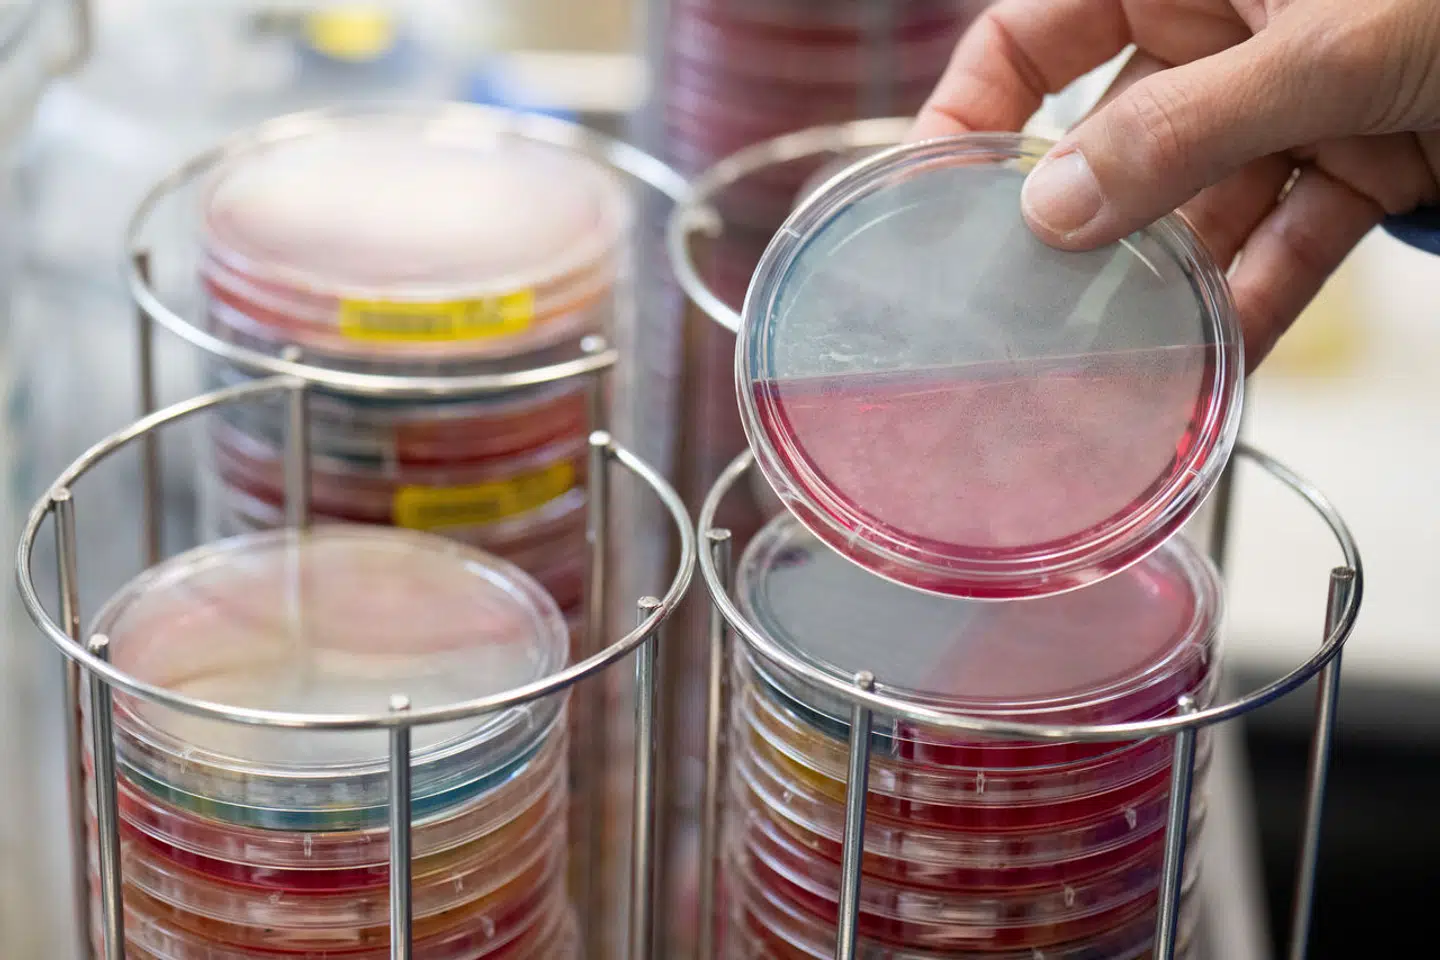
Det sjældne fænomen skyldtes en ubalance i kvindens mikrobiom. Arkivfoto: Boris Roessler, Scanpix

Kort nyt. Nyt studie viser, hvordan en 50-årig kvinde blev fuld igen og igen uden at drikke.
Ufrivilligt fuld
Det lyder som en absurd filmsketch. En canadisk kvinde på 50 år besøger skadestuen og sin praktiserende læge igen og igen. Hun er ekstremt træt, svimmel og desorienteret, fortæller hun med sløret stemme. Hun stinker af alkohol, er omtåget og uligevægtig.
Til ingens overraskelse viser undersøgelser af kvinden, at hun har store mængder alkohol i sit system, men hun nægter pure at have drukket; hun er afholdsmenneske af religiøse årsager, siger hun. Kvinden undersøges af psykiatere, der flere gange konkluderer, at hun ikke opfylder kriterierne for alkoholisme.
Til sidst tilses kvinden af en læge, der har et bud på en mulig forklaring: auto brewery syndrome (ABS), en usædvanlig medicinsk tilstand, hvor fordøjelsessystemet fermenterer kulhydrater og producerer berusende mængder ætanol som følge af infektion med gærsvampe og bakterier.
Auto brewery syndrome er en ekstremt sjælden lidelse; under 100 tilfælde er beskrevet, siden sygdommen blev opdaget i 1946. Af samme årsag udfoldes den canadiske kvindes forløb nu i en videnskabelig artikel.
Ifølge forskerne er den mest sandsynlige forklaring på kvindens auto brewery syndrome, at hendes mikrobiom var i ubalance som følge af et vedvarende og langvarigt forbrug af antibiotika på grund af gentagen blærebetændelse. Hun blev siden behandlet effektivt med mælkesyrebakterier og følger nu en stram diæt stort set uden kulhydrater.
For godt en måned siden blev en belgisk mand frifundet for spritkørsel, da det kom frem, at han under den påståede forseelse ikke var påvirket af indtaget alkohol, men af auto brewery syndrome.
Canadian Medical Association, 3. juni
The Telegraph, 3. juni
Jyllands-Posten, 24. april
Del:



